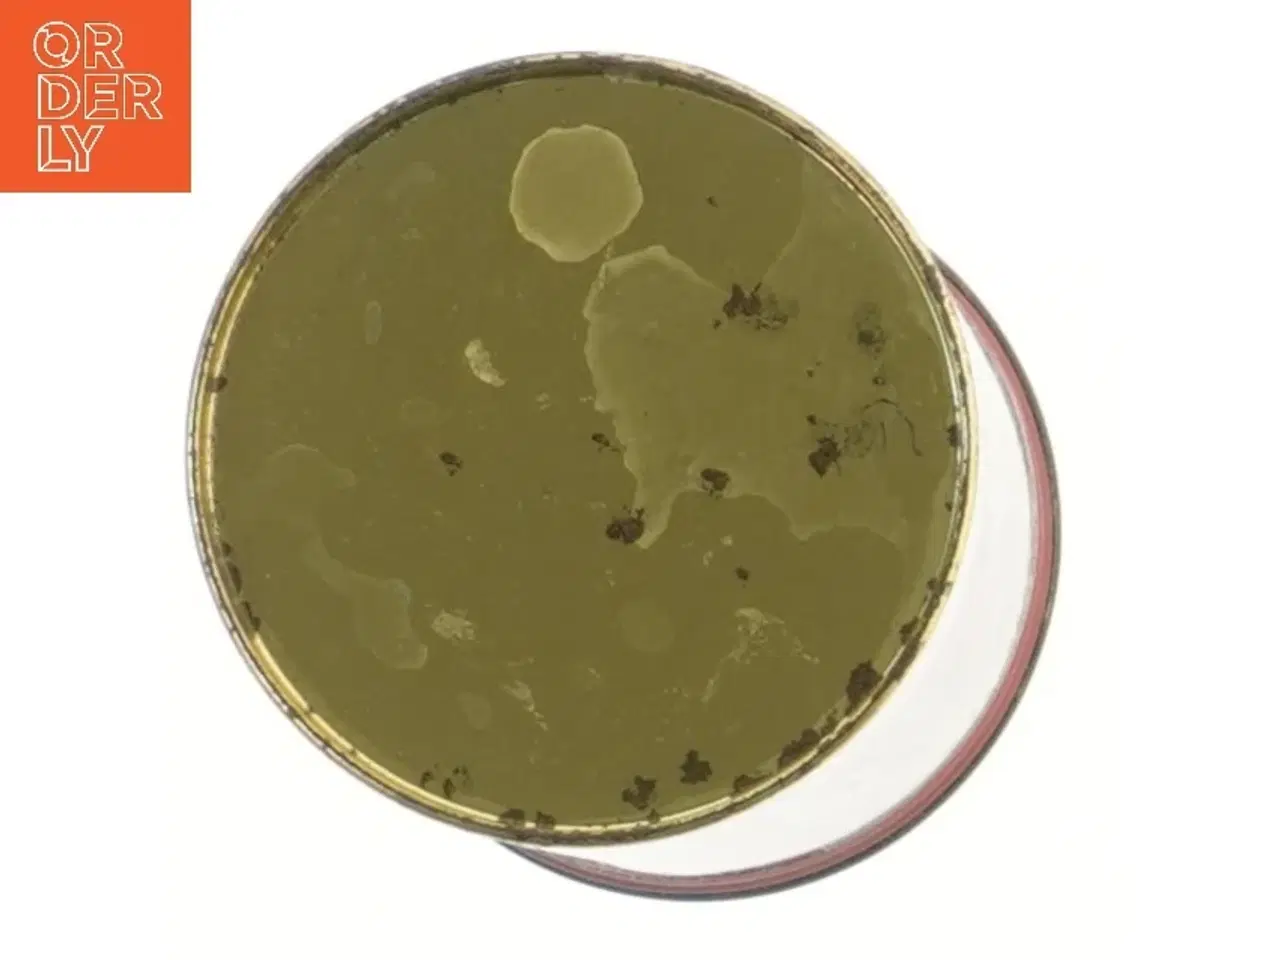
Billede 3 - Chokolade dåse fra Ph. Suchard (str. 14x9 cm)

Chokolade dåse fra Ph. Suchard (str. 14x9 cm)
60 kr.
Klik på 'Se annoncen hos forhandleren' for at se varen i vores webshop Denne runde chokolade dåse fra Ph. Suchard har et vintage design med et maleri på forsiden. Dåsen er lavet af metal og har en rød farve med detaljer af mærket på toppen. Den har en størrelse på 14x9 cm og er ideel til opbevaring som en dekorativ samlerobjekt. Brand: Ukendt Farve: rød Stand: 40 - Synligt slid fra almindelig brug (Se billeder) Vi sender til hele landet for 49 kr. Leveringstiden er 1-3 hverdage. Du kan også gratis hente den på vores lager på Industrivej 10 i Slangerup. Er du i tvivl om varen stadig er til salg? Klik på knappen "Se annoncen hos forhandleren" for at se den i vores webshop. Kan du se den der, er den stadig til salg Orderly er en ny måde at købe brugt på. Vi har alle vores sælgeres ting på vores centrale lager. Derfor kan du være helt sikker på at få dine ting - og du kan samle flere ting på tværs af sælgere og kun betale én gang fragt.
Se annoncen hos forhandleren
Orderly Shop
Send med priser fra 44 kr.
Køb fragt hos Gul&Gratis